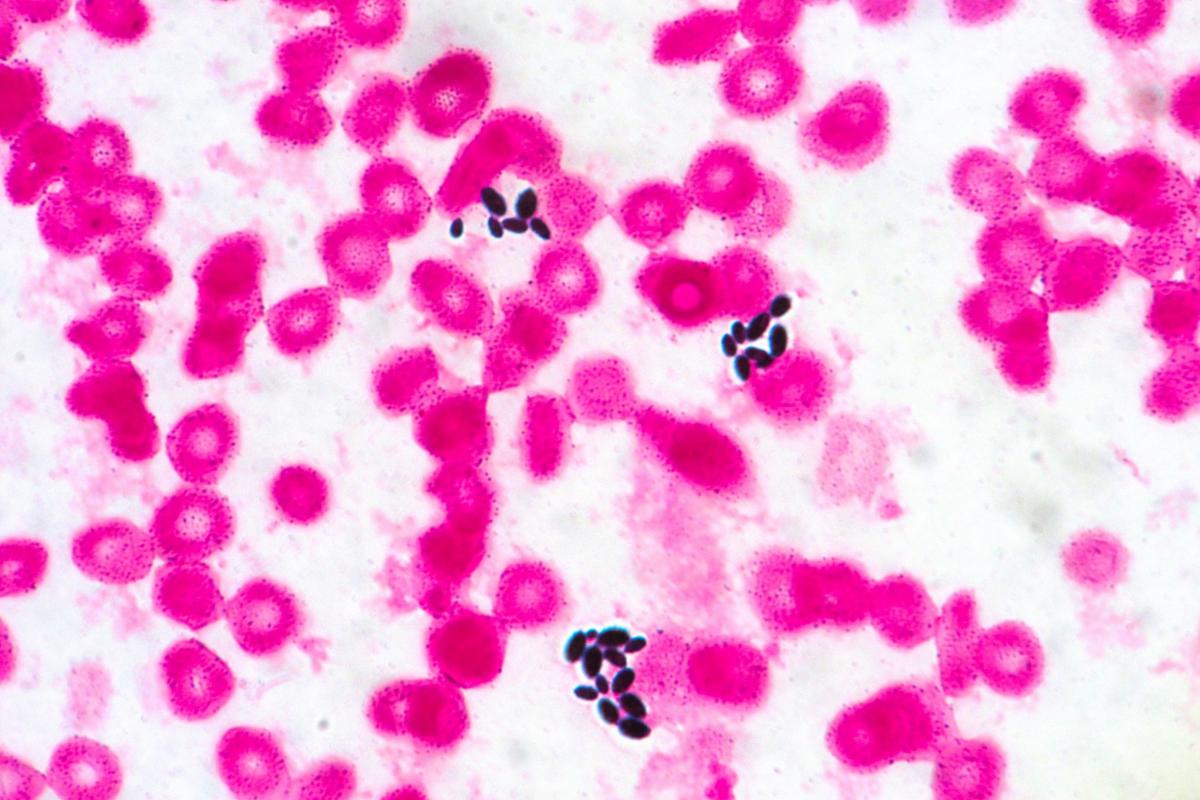

Candida parapsilosis: qué es, síntomas y tratamiento del hongo que se está expandiendo por los hospitales en España
Investigadores del Centro Nacional de Microbiología del Instituto de Salud Carlos III han detectado este hongo en varios centros hospitalarios.
Una investigación llevada a cabo desde el Centro Nacional de Microbiología del Instituto de Salud Carlos III ha detectado en los últimos años en varios hospitales españoles la aparición de clones del hongo Candida Parapsilosis resistentes a la terapia con azoles, lo que ha generado brotes de infecciones resistentes al tratamiento con estos fármacos.
Qué es la ‘Candida parapsilosis’
El hongo Candida parapsilosis es una causa frecuente de candidiasis, una infección que suele producirse en entornos hospitalarios y que está asociada al uso de implantes médicos, catéteres y vías de administración parenteral.
Las personas hospitalizadas, inmunodeprimidas, tratadas con antibióticos durante tiempo prolongado y los pacientes con otras enfermedades tienen más riesgo de sufrir estas infecciones, que pueden ser de carácter leve pero que, si no se tratan, puede generar graves complicaciones.
Las infecciones causadas por la Candida parapsilosis son la cuarta causa más común de infecciones en la sangre y cuentan con una tasa de mortalidad del 40% entre los pacientes que presentan defensas bajas.
Síntomas y tratamiento de la Candida parapsilosis
Aunque la Candida parapsilosis acostrumbra a manifestarse de forma leve, puede complicarse con rapidez. Identificar los síntomas puede ayudar a controlar la enfermedad:
- Erupciones de color rojo.
- Erupciones dolorosas, que pueden afectar principalmente a ojos, boca, vagina o uñas.
- Afección e irritación en membranas internas del organismo.
- Irritación del sistema digestivo cuando esta infección fúngica se da principalmente en este.
- Dolor abdominal en casos graves de infección en el sistema digestivo.
Para tratar la Candida parapsilosis lo primero que hay que hacer es suprimir el consumo de antibióticos, eliminar los dispositivos médicos de nuestro cuerpo y, en el caso de las mujeres, anticonceptivos intravaginales.
El medicamento que ha demostrado ser más efectivo contra la Candida parapsilosis es el fluconazol, que debe tomarse bajo supervisión médica. Esete tratamiento ataca directamente a los hongos y apenas tiene efectos secundarios.
¿Relación con la pandemia?
La investigación ha mostrado también que las cepas resistentes se pueden asociara a determinadas regiones geográficas. En concreto, De los 121 clones registrados en total en el estudio, los aislados resistentes y causantes de los brotes se agrupaban principalmente en tres genotipos, que se han presentado en hospitales de Cataluña, Madrid y Cantabria. Además, los autores también han detectado que algunos de estos clones también se han extendido a otras comunidades autónomas.
Aunque el incremento en la detección de estos clones se ha producido a partir de 2020, este tipo de aislados resistentes ya circulaban por algunos hospitales en 2019. Aún no se conocen las causas que han originado este aumento en su incidencia, aunque hay una coincidencia temporal con la pandemia de la COVID-19.
Por ello, los investigadores plantean la hipótesis que la selección y amplificación de clones resistentes de Candida parapsilosis puede haber sido un efecto secundario de la situación hospitalaria generada por el impacto de la pandemia.